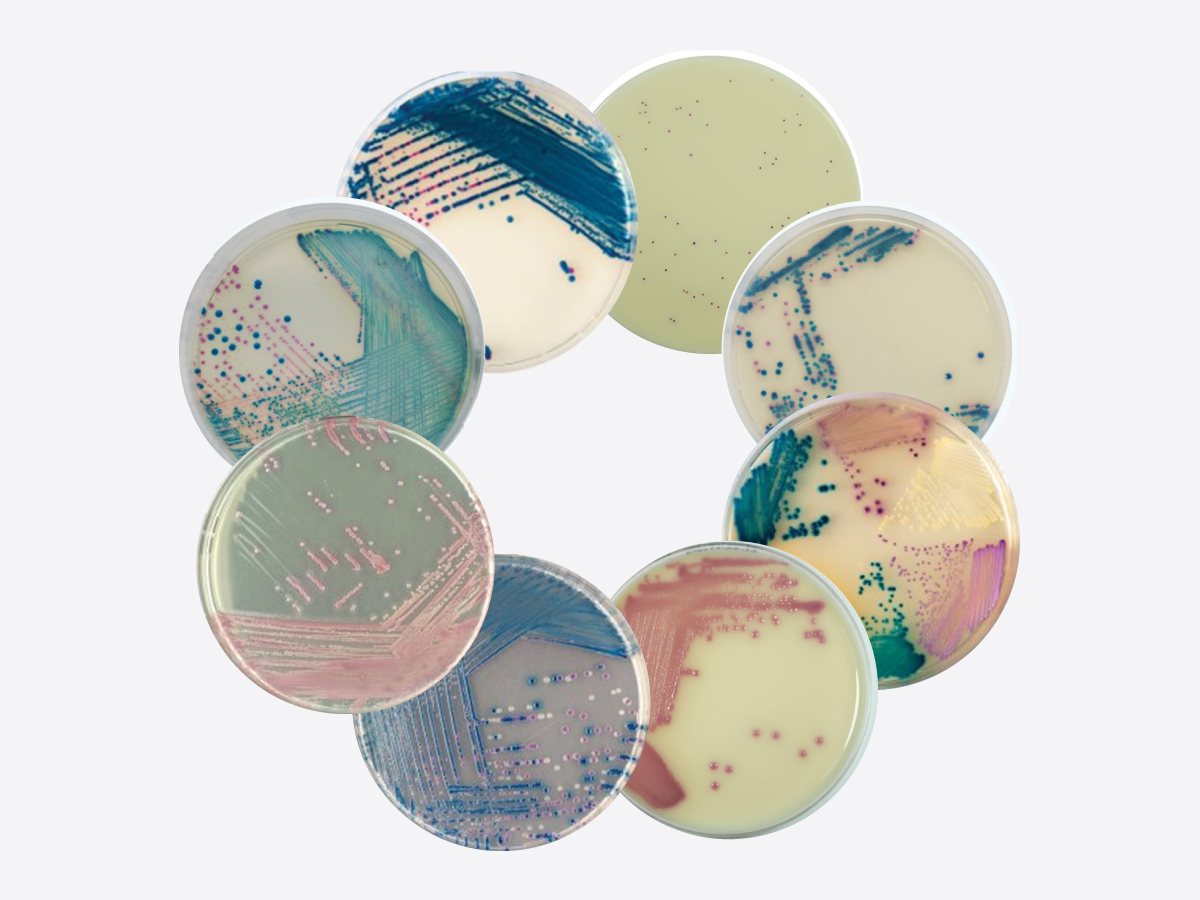
Môi trường sinh màu đĩa 90

ĐĨA - PLATE
Môi trường nuôi cấy vi sinh, kiểm soát môi trường sẵn sử dụng; Loại đĩa 90, 60 và đĩa contact; Loại đĩa 1 ngăn, 2 ngăn và 3 ngăn; Đóng gói 1 lớp hoặc 3 lớp; Có chiếu xạ hoặc không chiếu xạ tia gamma

Đĩa 90
Môi trường sinh màu đĩa 90

Đĩa contact

Đĩa 90, lấy mẫu môi trường

